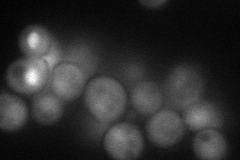

View description
Putative class I histone deacetylase (HDAC) with sequence similarity to Hda1p, Rpd3p, Hos2p, and Hos3p; deletion results in increased histone acetylation at rDNA repeats; interacts with the Tup1p-Ssn6p corepressor complex
Localization:
Intensity:
Fold change:
Significance:
-
C’ GFP library in SD

below threshold17 -
N' NOP1pr-GFP in SD
cytosol,nucleus67.4408 -
N' TEF2pr-mCherry in SD

nucleus73.3321 -
N' NATIVEpr-GFP in SD

cytosol19.542 -
N' TEF2pr-VC and Cyto-VN in SD

#N/A0 -
C’ GFP library in SD+DTT

cytosol19.751.16No -
C’ GFP library in SD+H2O2

cytosol21.151.24No -
C’ GFP library in Starvation Media

cytosol17.351.02No -
C’ GFP library on the background of Pup2-DaMP

below threshold -
C’ GFP library on the background of CCT mutant

below threshold17.01641.00023No
